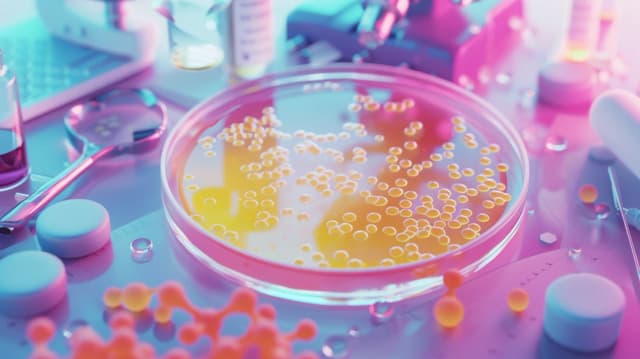

Dowiedz się, jakie badania na kandydozę Candida warto wykonać przy podejrzeniu infekcji grzybiczej. Poznaj metody diagnostyczne, skuteczne leczenie i profilaktykę grzybicy.
Dowiedz się, jakie badania na kandydozę Candida warto wykonać przy podejrzeniu infekcji grzybiczej. Poznaj metody diagnostyczne, skuteczne leczenie i profilaktykę grzybicy.
Biorezonans budzi kontrowersje - sprawdź, co mówią najnowsze badania naukowe o skuteczności tej metody w leczeniu różnych schorzeń. Czy biorezonans pomoże na choroby autoimmunologiczne?
Atopowe zapalenie skóry co to za schorzenie? Poznaj przyczyny, charakterystyczne objawy i skuteczne metody leczenia atopowego zapalenia skóry. Sprawdź, jak opanować tę przewlekłą chorobę.
Autoimmunologiczne zapalenie jelit to groźna choroba, w której układ odpornościowy atakuje tkanki jelit. Dowiedz się o przyczynach, objawach, leczeniu i diecie. Poznaj również powikłania, takie jak przetoki, utrata masy ciała i autoimmunologiczne zapalenie stawów.
Autoimmunologia to stan, gdy układ odpornościowy atakuje własne tkanki. Poznaj przyczyny takich autoimmunologicznych zaburzeń, objawy i metody diagnostyczne oraz leczenie chorób autoimmunologicznych.
Dowiedz się, czym są antygeny i jaką rolę pełnią w ludzkim organizmie. Antygeny to cząsteczki rozpoznawane przez układ odpornościowy jako obce lub niebezpieczne, inicjujące odpowiedź immunologiczną przeciwko patogenom.
Dowiedz się, jakie nabiały można spożywać, a których unikać podczas antybiotykoterapii. Poznaj wpływ antybiotyków na wchłanianie składników z produktów mlecznych i sposoby na bezpieczne przyjmowanie osłony przeciwbakteryjnej.
Dowiedz się, kiedy należy przyjmować antybiotyk i kiedy antybiotyk kiedy brać. Poznaj wskazania i sytuacje, w których antybiotyki są skuteczne i bezpieczne w leczeniu infekcji.
Dowiedz się, dlaczego ważne jest prawidłowe wykonanie badania krwi po antybiotyku i jak się do niego przygotować. Sprawdź, jakie parametry mogą ulec zmianie po kuracji antybiotykowej.
Poznaj główne alergeny wziewne i czynniki wywołujące reakcje alergiczne. Od pyłków roślin po roztocza kurzu domowego - dowiedz się, jak chronić się przed alergenami i lepiej radzić sobie z objawami alergii wziewnej.